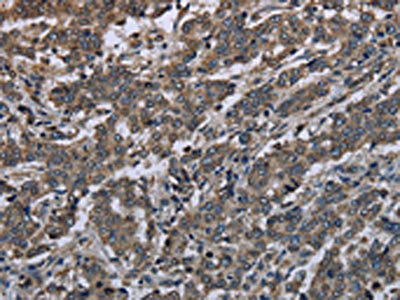

MAPKAPK2 Antibody
-
中文名稱:MAPKAPK2兔多克隆抗體
-
貨號:CSB-PA557048
-
規格:¥1100
-
圖片:
-
The image on the left is immunohistochemistry of paraffin-embedded Human liver cancer tissue using CSB-PA557048(MAPKAPK2 Antibody) at dilution 1/20, on the right is treated with synthetic peptide. (Original magnification: ×200)
-
The image on the left is immunohistochemistry of paraffin-embedded Human colon cancer tissue using CSB-PA557048(MAPKAPK2 Antibody) at dilution 1/20, on the right is treated with synthetic peptide. (Original magnification: ×200)
-
Gel: 8%SDS-PAGE, Lysate: 40 μg, Lane 1-2: Human chromaffin cell tumor tissue, A431 cells, Primary antibody: CSB-PA557048(MAPKAPK2 Antibody) at dilution 1/350, Secondary antibody: Goat anti rabbit IgG at 1/8000 dilution, Exposure time: 6 minutes
-
-
其他:
產品詳情
-
Uniprot No.:
-
基因名:
-
別名:MAP kinase activated protein Kinase 2 antibody; MAP kinase-activated protein kinase 2 antibody; MAPK activated protein kinase 2 antibody; MAPK-activated protein kinase 2 antibody; MAPK2_HUMAN antibody; MAPKAP K2 antibody; MAPKAP kinase 2 antibody; MAPKAPK 2 antibody; MAPKAPK-2 antibody; MAPKAPK2 antibody; Mitogen activated protein kinase activated protein kinase 2 antibody; MK 2 antibody; MK2 antibody
-
宿主:Rabbit
-
反應種屬:Human,Mouse
-
免疫原:Synthetic peptide of Human MAPKAPK2
-
免疫原種屬:Homo sapiens (Human)
-
標記方式:Non-conjugated
-
抗體亞型:IgG
-
純化方式:Antigen affinity purification
-
濃度:It differs from different batches. Please contact us to confirm it.
-
保存緩沖液:-20°C, pH7.4 PBS, 0.05% NaN3, 40% Glycerol
-
產品提供形式:Liquid
-
應用范圍:ELISA,WB,IHC
-
推薦稀釋比:
Application Recommended Dilution ELISA 1:1000-1:2000 WB 1:200-1:1000 IHC 1:25-1:100 -
Protocols:
-
儲存條件:Upon receipt, store at -20°C or -80°C. Avoid repeated freeze.
-
貨期:Basically, we can dispatch the products out in 1-3 working days after receiving your orders. Delivery time maybe differs from different purchasing way or location, please kindly consult your local distributors for specific delivery time.
-
用途:For Research Use Only. Not for use in diagnostic or therapeutic procedures.
相關產品
靶點詳情
-
功能:Stress-activated serine/threonine-protein kinase involved in cytokine production, endocytosis, reorganization of the cytoskeleton, cell migration, cell cycle control, chromatin remodeling, DNA damage response and transcriptional regulation. Following stress, it is phosphorylated and activated by MAP kinase p38-alpha/MAPK14, leading to phosphorylation of substrates. Phosphorylates serine in the peptide sequence, Hyd-X-R-X(2)-S, where Hyd is a large hydrophobic residue. Phosphorylates ALOX5, CDC25B, CDC25C, CEP131, ELAVL1, HNRNPA0, HSP27/HSPB1, KRT18, KRT20, LIMK1, LSP1, PABPC1, PARN, PDE4A, RCSD1, RPS6KA3, TAB3 and TTP/ZFP36. Phosphorylates HSF1; leading to the interaction with HSP90 proteins and inhibiting HSF1 homotrimerization, DNA-binding and transactivation activities. Mediates phosphorylation of HSP27/HSPB1 in response to stress, leading to the dissociation of HSP27/HSPB1 from large small heat-shock protein (sHsps) oligomers and impairment of their chaperone activities and ability to protect against oxidative stress effectively. Involved in inflammatory response by regulating tumor necrosis factor (TNF) and IL6 production post-transcriptionally: acts by phosphorylating AU-rich elements (AREs)-binding proteins ELAVL1, HNRNPA0, PABPC1 and TTP/ZFP36, leading to the regulation of the stability and translation of TNF and IL6 mRNAs. Phosphorylation of TTP/ZFP36, a major post-transcriptional regulator of TNF, promotes its binding to 14-3-3 proteins and reduces its ARE mRNA affinity, leading to inhibition of dependent degradation of ARE-containing transcripts. Phosphorylates CEP131 in response to cellular stress induced by ultraviolet irradiation which promotes binding of CEP131 to 14-3-3 proteins and inhibits formation of novel centriolar satellites. Also involved in late G2/M checkpoint following DNA damage through a process of post-transcriptional mRNA stabilization: following DNA damage, relocalizes from nucleus to cytoplasm and phosphorylates HNRNPA0 and PARN, leading to stabilization of GADD45A mRNA. Involved in toll-like receptor signaling pathway (TLR) in dendritic cells: required for acute TLR-induced macropinocytosis by phosphorylating and activating RPS6KA3.
-
基因功能參考文獻:
- Study found an elevated expression level of MK2 in serum specimens of patients with spinal cord injury. MiR-137 targets MK2 and inhibits its mediated inflammatory response and apoptosis after spinal cord injury. PMID: 29125882
- The novel MK2 substrates have emerged in the DNA damage response, autophagy, and obesity, making MK2 a multifunctional kinase at the crossroads of stress response and cell death. PMID: 29275999
- According to the information mentioned above, we now report the design and synthesis of some series of new urea derivatives that were then evaluated for their inhibitory activities against MAPKAPK2, TNF-a, and p38a PMID: 27223276
- MK2 post-transcriptionally regulates TNF-alpha-induced ICAM-1 expression by altering the cytoplasmic localization of HuR in human lung microvascular endothelial cells. PMID: 27215284
- MK2 overexpression is associated with primary liver tumors. PMID: 26169728
- mTOR controls the senescence-associated secretory phenotype by differentially regulating the translation of the MK2 (also known as MAPKAPK2). PMID: 26280535
- analysis of signaling cooperation between p38-MAPK/MAPKAP-2/Hsp27 and intracellular calcium release in AA-induced HBEC apoptosis PMID: 24802256
- Low pMK2 expression was found to correlate significantly with overall survival after induction plus chemoradiation therapy in head and neck squamous cell carcinoma patients. PMID: 25019640
- The protein expression of both HMGB1 and MAPKAPK2 were increased in KLM1-R cells. PMID: 26124331
- Data indicate the binding mode and molecular mechanism of action of MAPK-activated protein kinase-2 (MK2) and inhibitors. PMID: 25255283
- Treatment with MK2 or p38 inhibitors blocked human papillomavirus genome amplification, identifying the p38/MK2 pathway as a key regulator of the human papillomavirus life cycle. PMID: 25410865
- a key role of MK2 and FasR in the regulation and limitation of the immune response in the CNS PMID: 24964076
- IscU is a new substrate of MK2 both in Drosophila cells and in human cells PMID: 25204651
- MK2 mediates gemcitabine efficacy in pancreatic cancer cells that respond to the drug, suggesting that the p38/MK2 pathway represents a determinant of the efficacy by that gemcitabine counteracts pancreatic cancer. PMID: 24556918
- MK2 plays a critical role in the development of apoptosis. PMID: 24304496
- ATM and MAPKAP kinase 2 mediate radiation sensitivity in pancreatic cancer cells via phosphorylation of TRIM29. PMID: 24469230
- the functional copy number variation 30450 in the MAPKAPK2 promoter elevates the nasopharyngeal carcinoma risk with a modulation by EBV infection PMID: 24056810
- These data suggest that MK2 is a key downstream effector of p38 that can modulate pemphigus vulgaris autoantibody pathogenicity. PMID: 23657501
- MK2 activity was required for damage response, accumulation of ssDNA, and decreased survival when cells were treated with the nucleoside analogue gemcitabine or when the checkpoint kinase Chk1 was antagonized. PMID: 24082115
- MK2 gene rs45514798 polymorphisms may be associated with HDL-C in Uygur men younger than 50 years old from Hetian area of Xinjiang. PMID: 23744329
- Kaposin B significantly contributes to the chronic inflammatory environment by unique activation of the proto-oncogene STAT3, coupled with MK2-mediated inactivation of the STAT3 transcriptional repressor TRIM28. PMID: 23740979
- activation of PP2A or inactivation of the p38MAPK-MAPKAPK2-Hsp27 has a role in survival of cancer stem cells under hypoxia and serum depletion via decrease in PP2A activity PMID: 23185379
- This study showed that MK2 kinase is activated by TcdA and TcdB and regulates the expression of proinflammatory cytokines. PMID: 23264053
- Cigarette smoke and its component acrolein augment IL-8/CXCL8 mRNA stability via p38 MAPK/MK2 signaling in human pulmonary cells. PMID: 22983351
- A functional copy-number variation in MAPKAPK2 predicts risk and prognosis of lung cancer PMID: 22883146
- Data show that MAPKAP kinase 2 overexpression is associated with expression of p38 MAP kinase and ETV1 in gastrointestinal stromal tumors (GIST). PMID: 22351694
- analysis of inhibition of human MK2 PMID: 22119462
- TLR3 induces signaling mechanisms involving TRIF, p38 MAPK and MK2 to enhance stabilization of IFN-beta mRNA contributing to enhanced IFN-beta levels during pathogen infections. PMID: 22200507
- MK2 SUMOylation is a new mechanism for regulating actin filament dynamics in ECs. PMID: 21131586
- Demonstrate a critical role for the MK2 pathway in the posttranscriptional regulation of gene expression as part of the DNA damage response in cancer cells. PMID: 20932473
- MK2 phosphorylation reduces the ability of TTP to promote deadenylation by inhibiting the recruitment of CAF1 deadenylase in a mechanism that does not involve sequestration of TTP by 14-3-3. PMID: 20595389
- Tumor necrosis factor (TNF)-alpha protein, but not messenger RNA production, is markedly impaired by MK2 deficiency of transgenic mice. PMID: 20375303
- From a siRNA screen of the human kinome adapted to a high-throughput format, we found that knock-down of the MAPK-activated protein kinase 2 (MK2), a downstream target of the p38 MAPK, protected against Shiga toxicity. PMID: 19951368
- miR-34c is a critical regulator of c-Myc expression following DNA damage acting downstream of p38 MAPK/MK2, and miR-34c serves to remove c-Myc to prevent inappropriate replication which may otherwise lead to genomic instability. PMID: 20212154
- Data provide evidence that p38 Map kinase pathway is activated leading to increased upregulation of mixed lineage kinase 3, MKK3/6, MSK1, and Mapkapk2, upon treatment of BCR/ABL expressing cells with dasatinib PMID: 19672773
- Findings implicate p38 MAPK and MAPKAPK2 in mediating bladder cancer invasion via regulation of MMP-2 and MMP-9 at the level of mRNA stability. PMID: 20068172
- MK2 signaling has a minor role in skin inflammation [commentary] PMID: 20081887
- Examination of the kinetic mechanism PMID: 12147348
- structure suggests a bifunctional switch that couples kinase activation with nuclear export PMID: 12171911
- role in pathway that promotes urokinase plasminogen activator mRNA stability in invasive breast cancer cells PMID: 12377770
- MAPKAPK-2 and ERKs activate 5-lipoxygenase PMID: 12751751
- crystal structures of a catalytically active C-terminal deletion form of human MAP KAP kinase 2, residues 41-364, in complex with staurosporine at 2.7 A and with ADP at 3.2 A PMID: 12791252
- MK2 is activated with p66(ShcA) co-expression and p66(ShcA) is an in vitro substrate for MK2, further demonstrating their association and suggesting a biological role for p66(Shc) in MK2 activation PMID: 15094067
- BAG2 was directly phosphorylated at serine 20 in vitro by MAPKAPK2 and MAPKAP2 is also required for phosphorylation of BAG2 in vivo. PMID: 15271996
- The 30-amino acid docking domain peptide of MAPKAPK2 isoform a (MK2a) is required for the formation of a tight, functional p38alpha-MK2a signaling complex. PMID: 15287722
- MAPKAP kinase-2 is directly responsible for Cdc25B/C phosphorylation and 14-3-3 binding in vitro and in response to UV-induced DNA damage. PMID: 15629715
- Kaposin B reverses the instability of cytokine trnscripts by binding to and activating mitogen-activated protein kinase-associated protein kinase 2, a target of the p38 mitogen-activated protein kinase signaling pathway and inhibitor of ARE-mRNA decay PMID: 15692053
- HSF1 phosphorylation by MAPK-activated protein kinase 2 on serine 121, inhibits transcriptional activity and promotes HSP90 binding PMID: 16278218
- Both MAPKAPK2 and HSP27 are necessary for TGFbeta-mediated increases in MMP-2 and cell invasion in human prostate cancer. PMID: 16407830
- Increased activation of MAPKAP2 is responsible for elevated and posttranscriptionally regulated TNF-alpha protein expression in psoriatic skin. PMID: 16424170
顯示更多
收起更多
-
亞細胞定位:Cytoplasm. Nucleus. Note=Phosphorylation and subsequent activation releases the autoinhibitory helix, resulting in the export from the nucleus into the cytoplasm.
-
蛋白家族:Protein kinase superfamily, CAMK Ser/Thr protein kinase family
-
組織特異性:Expressed in all tissues examined.
-
數據庫鏈接:
Most popular with customers
-
-
YWHAB Recombinant Monoclonal Antibody
Applications: ELISA, WB, IHC, IF, FC
Species Reactivity: Human, Mouse, Rat
-
Phospho-YAP1 (S127) Recombinant Monoclonal Antibody
Applications: ELISA, WB, IHC
Species Reactivity: Human
-
-
-
-
-